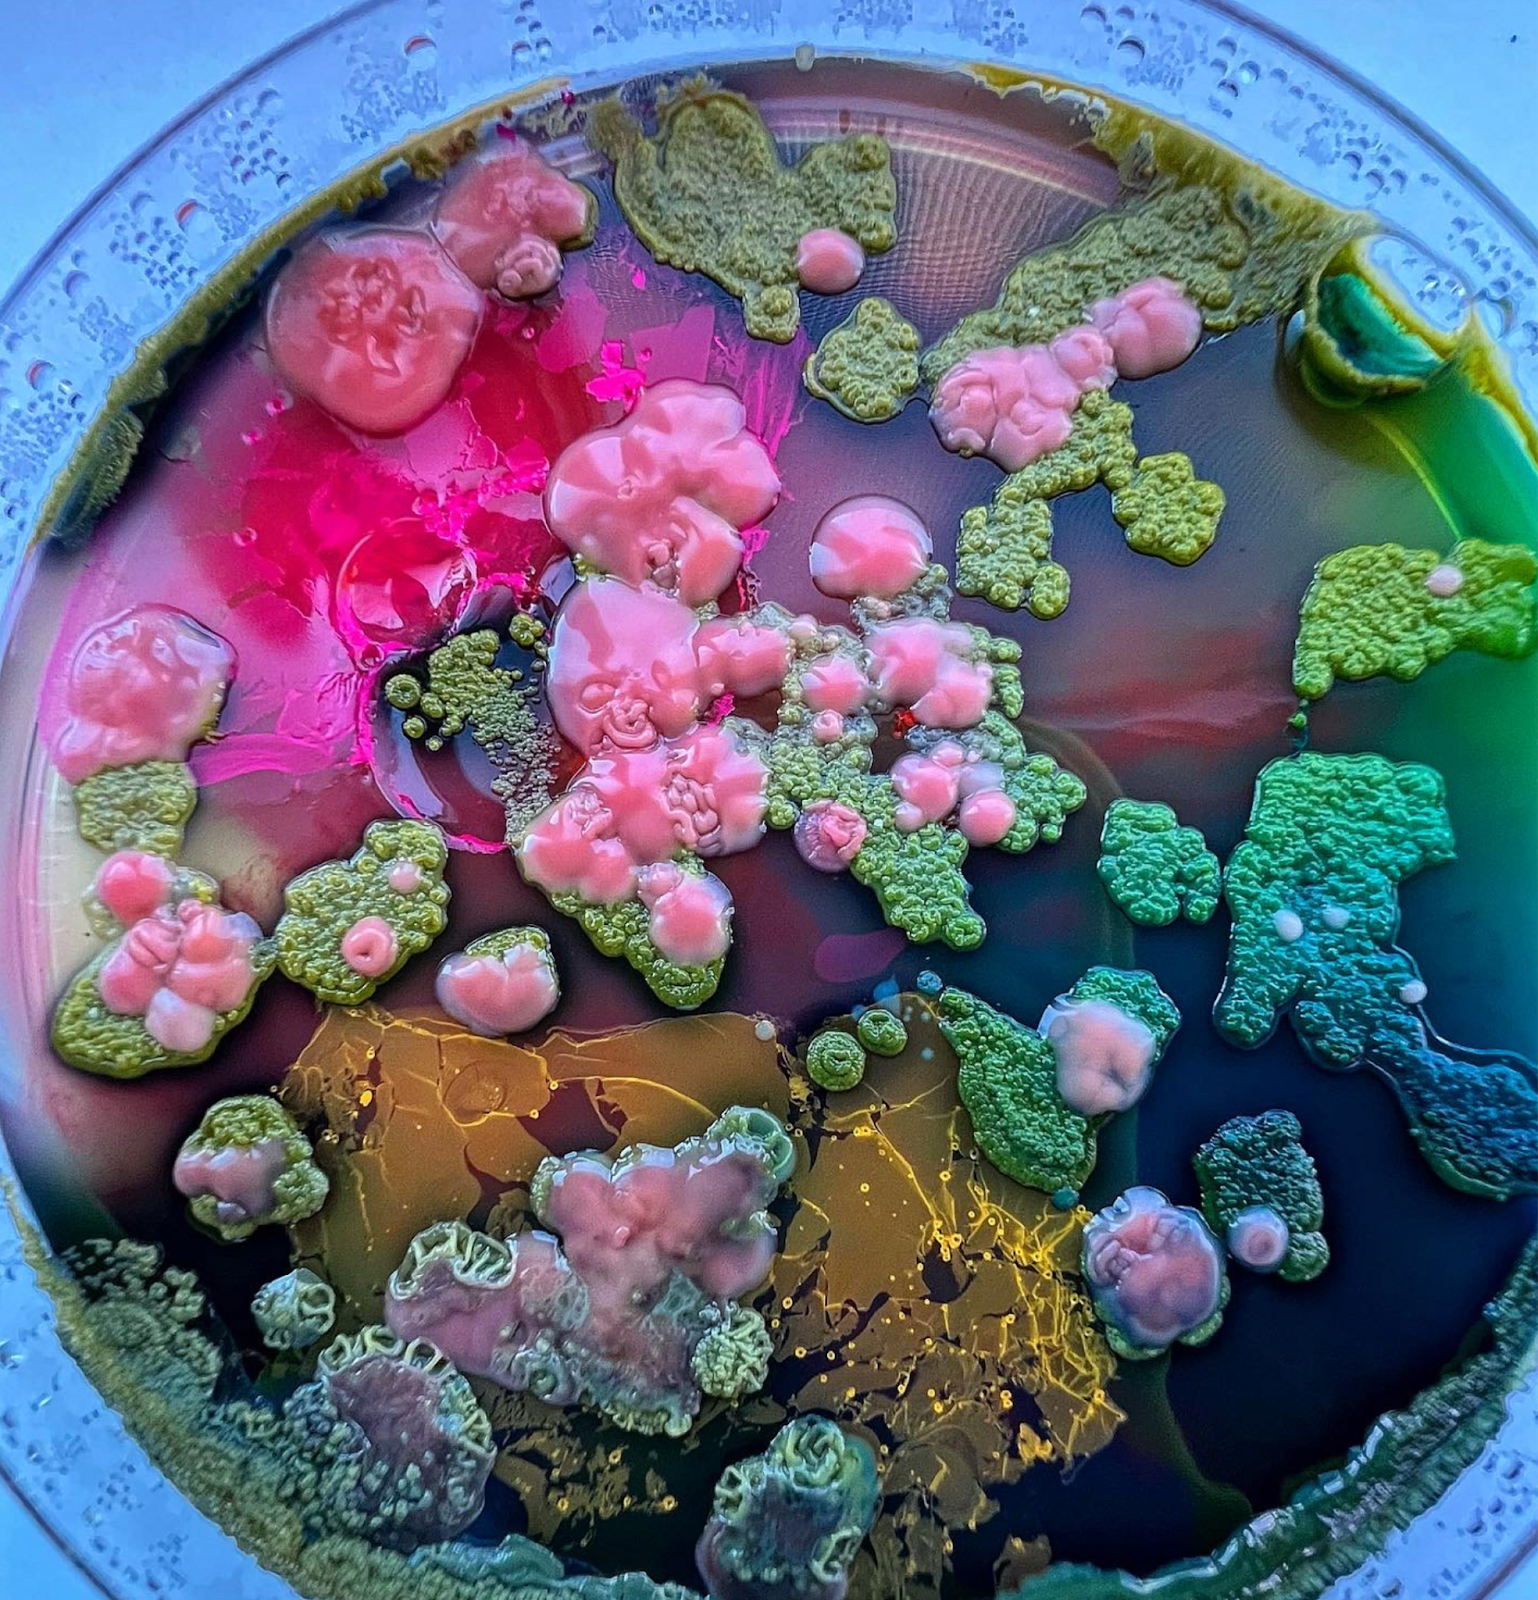
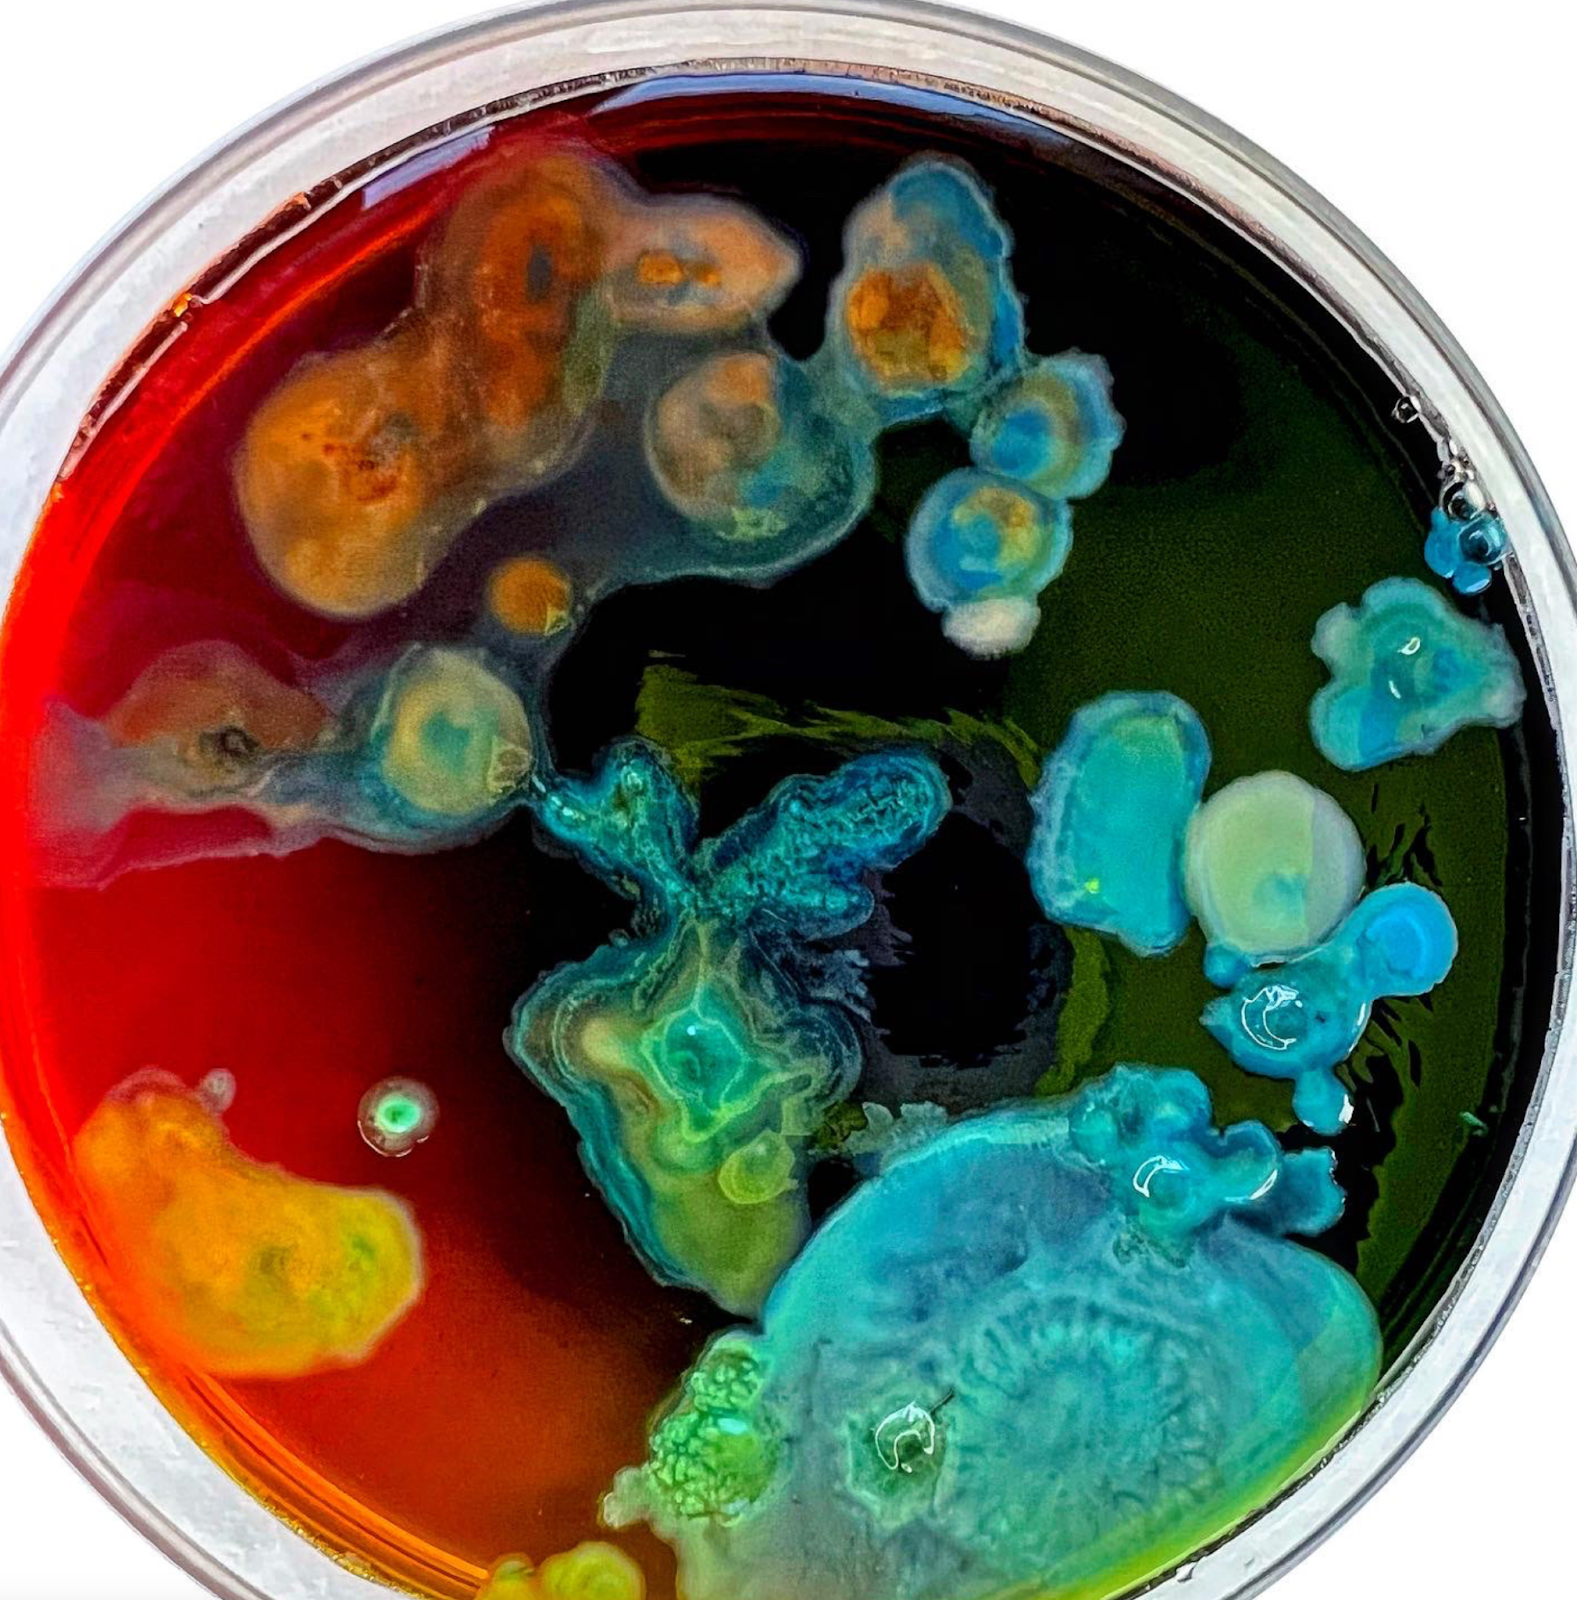

Textile artist - sugar & slime - fermented materials >> about β Sugar and Slime ππππππππͺ‘πͺ‘πͺ‘πͺ‘πͺ‘πͺ‘πͺ‘πͺ‘πͺ‘πͺ‘πͺ‘πͺ‘πͺ‘πͺ‘πͺ‘πͺ‘πͺ‘πͺ‘πͺ‘πͺ‘πͺ‘πͺ‘π¬π¬π¬π¬π¬π¬π¬π¬π¦ π¦ π¦ π¦ π¦ π¦ π¦ π¦
The Fabric of Reality: The Science of Parallel Universes--and Its Implications by David Deutsch | Goodreads πβοΈβοΈβοΈβοΈβοΈ Uzumaki
Food, woods, matte, pizza oven ππππππππππππππͺ΅πͺ΅πͺ΅πͺ΅πͺ΅πͺ΅πͺ΅π²π²π²π²π²π²π²π²π²π²π²π²π²π²π§π§π§π§π§π§π§π§π§π§π§
Chocolate chocolate chocolate - pastiera - more food!

Journey to the Microcosmos - YouTube


ππππ ππππππππ (@soft.surprise) β’ Instagram photos and videos
GitHub - hype/HYPE_Processing: HYPE for Processing
BOOK >>>> ππππππΒ Β Mindstorms: children, computers, and powerful ideasπππππππππππ
StepS:
https://www.instagram.com/fabiojcortes/
https://www.instagram.com/theraspygiraffe/
https://sunbeam.city/@murilove
https://www.instagram.com/emilyfuhrman.co/
https://www.instagram.com/shalin979/
https://www.instagram.com/saga_gaga/ is me
https://www.instagram.com/ludalab_ Β is the team I'm a part of and where you can see most of my work
https://www.instagram.com/dazy_chains/
https://www.instagram.com/yadira.sz/